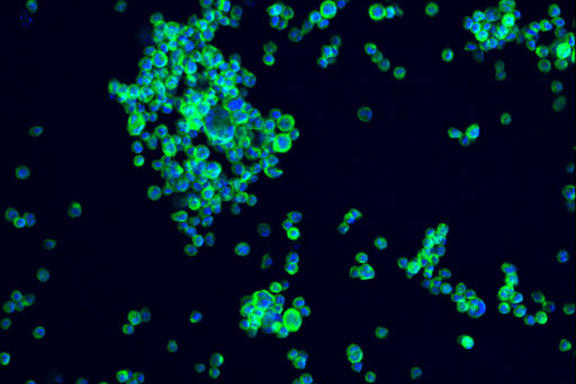

Driving Innovation
From developing precise atomic clocks to creating encryption standards to supporting manufacturing, NIST plays a crucial role in advancing technology.
What we do
From nanoscale devices that power the most advanced microchips to earthquake-resistant skyscrapers, NIST’s measurements and research fuel innovation and improve the quality of life for all Americans. We provide support and resources to U.S. manufacturing, helping to grow our economy and ensure our national security.
Discover how our work makes America safer, healthier and more prosperous.
America’s national measurement institute

NIST is the National Metrology Institute for the United States, also known as an NMI. Everything you use in your everyday life works because of measurements. Without precise measurements, your car wouldn’t run, your phone wouldn’t work, and hospitals couldn’t function. We maintain the measurements that make industry and society work. Learn more about our unique role in the national — and global — economy.

NIST in your inbox
Stay up to date with the latest news from NIST. Sign up for our Tech Beat newsletter or to get news about your favorite research topics.
Sign Up